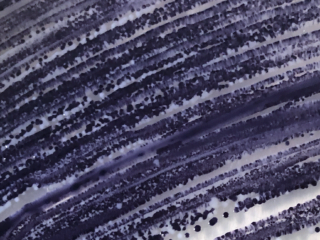

Search for large-scale climate-friendly building and living
The Exploded View Materials & Methods is an installation of a model home scale 1:4 made of circular and biobased materials and methods. This project models the fascinating existing and future possibilities of sustainable building: eggshell floors, hemp bricks, vulcanic mussel shell laminate, self healing fungal paint, fruit leather chairs and a toilet made from sewage waste are just a few examples.